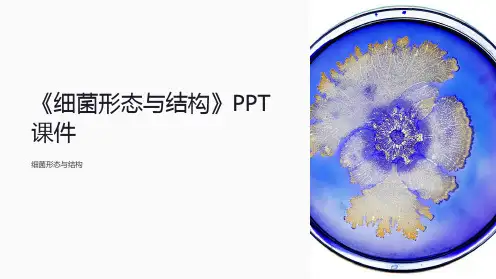

➢ 共有组分:肽聚糖(peptidoglycan)
▪ 革兰阳性菌 聚糖骨架、四肽侧链、五肽交联桥 三维立体结构,坚固 15~50层
▪ 革兰阴性菌 聚糖骨架、四肽侧链 二维平面结构,疏松 1~2层
(1) N-乙酰葡萄糖胺(NAG) 和 N- 乙酰胞壁酸(NAM) 由β1,4糖苷键合的二糖;
(2) 由L-丙氨酸, D-谷氨酸, L-赖 氨酸和D-丙氨酸组成四肽;
无核膜核核仁,也无组蛋白包绕,
*
故称拟核 细菌的遗传物质, 决定细菌性状
*
和遗传特征。
椰毒疽假单胞菌的拟核(*) DNA细丝() 伸入细胞质中
细菌的特殊结构(Special structure of bacteria)
荚膜(capsule)
细菌分泌到细胞壁外的粘稠性物质堆积形成一层 特殊的粘液物质结构。 1. 化学成分: 为多糖或多肽。 2. 生成条件: 机体内或营养丰富的培养基
▪双球菌(Diplococcus) ▪链球菌(Streptococcus)
第一节 细菌的大小与形态(Morphology of bacteria) 细菌的基本形态(Shape of Bacteria) 球菌 (coccus)
葡萄球菌(Staphylococcus) 四联球菌(Tetrads) 八叠球菌(Sarcina)
L-丙氨酸 D-谷氨酸 L-赖氨酸 D-丙氨酸
DAP: diaminopimelicacid 二-氨基庚二酸
溶菌酶作用点
N-乙酰葡萄糖胺 N-乙酰胞壁酸 b-1,4糖苷键
青霉素作用点
细菌的基本结构(Basic structures of bacteria) 细胞壁(cell wall)
➢ 特殊组分
细菌的基本形态(Shape of Bacteria)